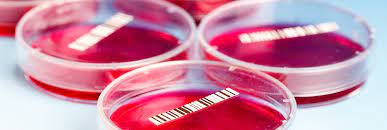

Kultur Gaal
Minggu, 27 April 2025 | 19:27Pemeriksaan gaal kultur adalah suatu pemeriksaan kultur darah untuk mencari bakteri Salmonella typhi.

Tinta India
Minggu, 27 April 2025 | 19:22Pemeriksaan dengan pewarnaan tinta india merupakan tes yang dilakukan untuk mendeteksi keberadaan jamur Kriptokokus neoformans.

Pemeriksaan Gonore
Minggu, 27 April 2025 | 18:12Pemeriksaan gonore adalah tes yang dilakukan untuk mendeteksi keberadaan bakteri gonore dalam sampel cairan tubuh.

Bakteri Tahan Asam (BTA)
Minggu, 27 April 2025 | 18:04Pemeriksaan BTA merupakan pemeriksaan laboratorium klinis yang dilakukan untuk membantu dalam menetapkan diagnosis penyakit TB.

CRP Kualitatif
Rabu, 27 November 2024 | 21:09CRP kualitatif adalah pemeriksaan untuk mengetahui adanya kondisi infeksi dan peradangan dalam tubuh.

Biakan MO Resisten Anaerob
Sabtu, 23 November 2024 | 15:29Biakan MO resisten anaerob adalah pemeriksaan bakteria resisten antibiotik tertentu pada suatu sampel tubuh
Biakan MO Resisten Aerob
Sabtu, 23 November 2024 | 15:22Pemeriksaan biakan MO resistensi aerob adalah pemeriksaan darah untuk menentukan apakah bakteria aerob sensitif terhadap antibiotik

Biakan Jamur
Sabtu, 23 November 2024 | 15:11Pemeriksaan biakan jamur dilakukan menggunakan sampel dari tubuh manusia untuk dibiakkan dalam media khusus

Antibodi TPO
Selasa, 19 November 2024 | 13:02Tiroid peroksidase atau TPO merupakan enzim yang dihasilkan oleh kelenjar tiroid, kelenjar berbentuk kupu-kupu yang terletak dibagian depan leher.

Anti-HBs
Selasa, 19 November 2024 | 11:51Anti-HBs adalah pemeriksaan untuk mengetahui adanya antibodi atau kekebalan terhadap virus hepatitis B.







